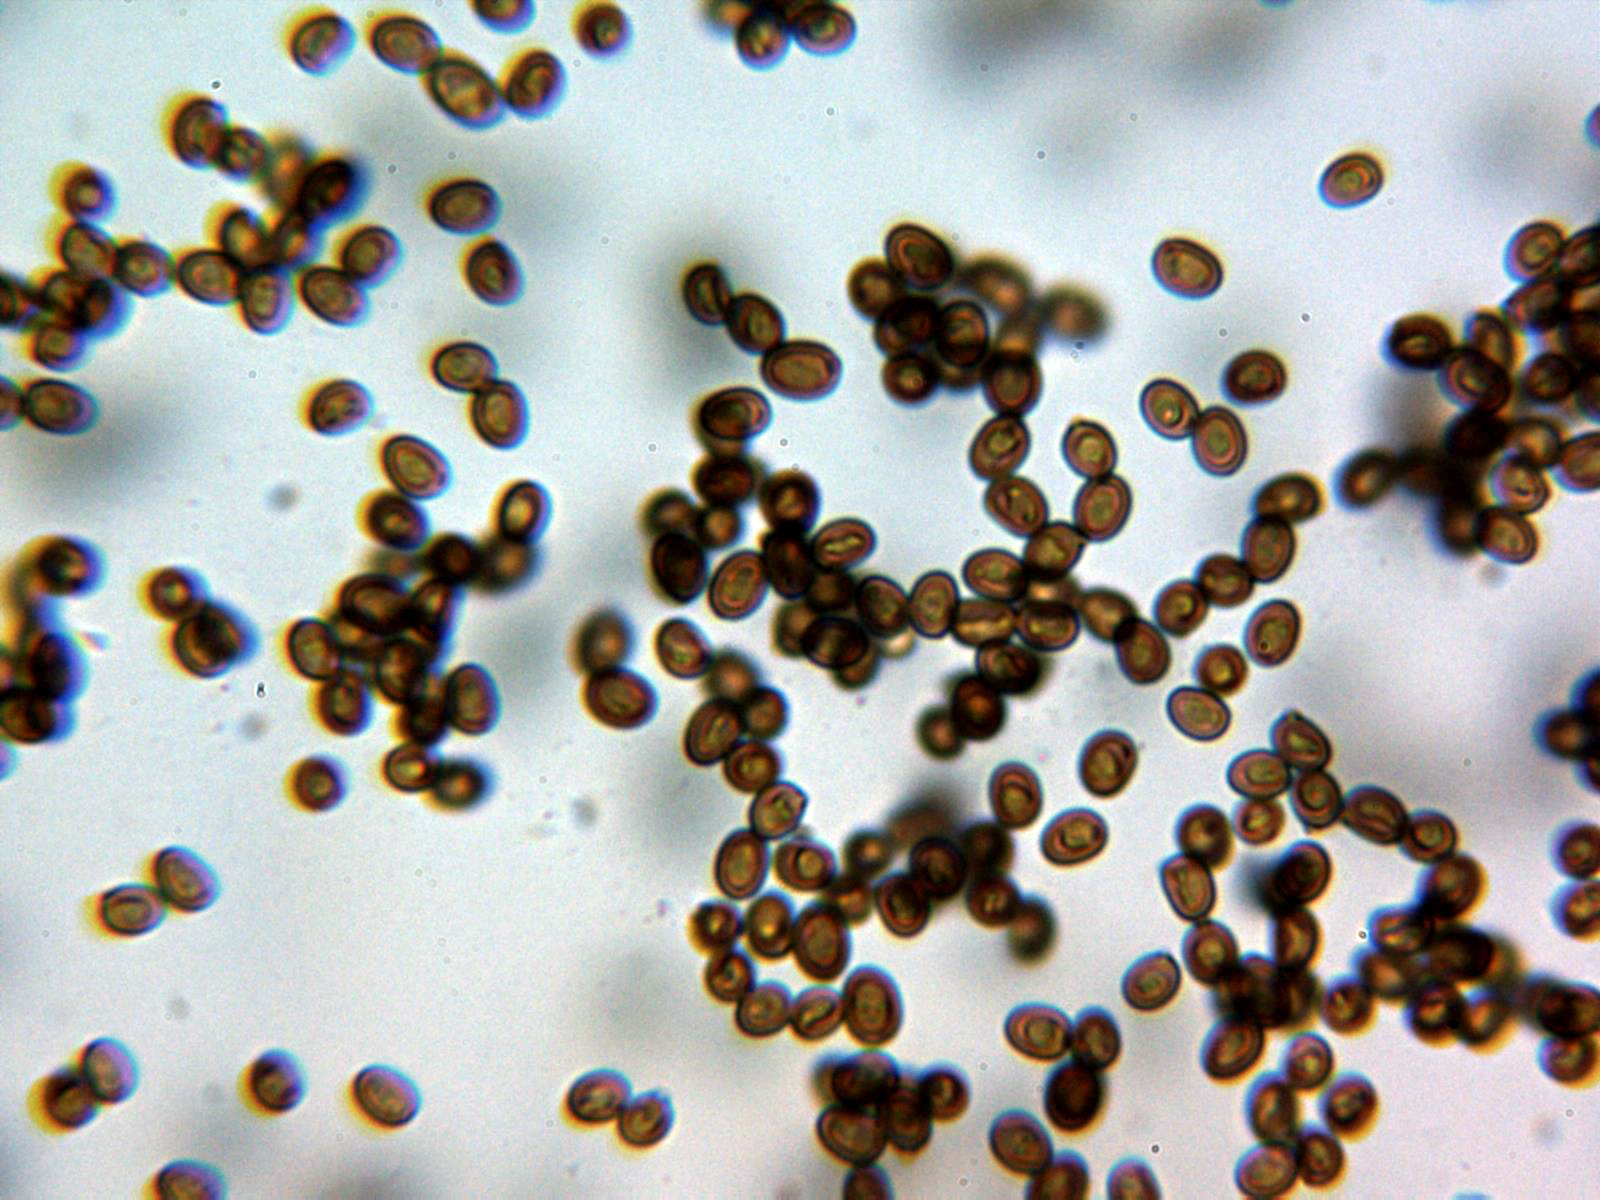

- Foro
- Foros sobre Micología de fungipedia
- Microscopía
- Agaricus semotus y más cosas del pasado domingo.
 Agaricus semotus y más cosas del pasado domingo.
Agaricus semotus y más cosas del pasado domingo.
- Josep Torres
-
 Autor del tema
Autor del tema
- Fuera de línea
- Moderador
-

Menos
Más
- Mensajes: 8746
- Gracias recibidas: 8379
4 años 6 meses antes #106292
por Josep Torres
Agaricus semotus y más cosas del pasado domingo. Publicado por Josep Torres
Hola a tod@s.
Un solo ejemplar de Agaricus de la sección Minores de unos 3 cm., con sombrero con tonos vinosos:
Agaricus semotus Fr. (1863)
Suprapellis en agua del grifo:
Hifas vesiculosas a modo de queilocistidios en la arista laminar, pleurocistidios no observados:
Himenio con basidios tetraspóricos:
Las esporas en agua de grifo:
Y las esporas en Reactivo de Melzer (dextrinoides):
Las esporas en agua con unas medidas de:
(3.9) 4.4 - 5.1 (5.5) × (3) 3.2 - 3.6 (3.8) µm
Q = (1.3) 1.31 - 1.5 (1.6) ; N = 40
Me = 4.7 × 3.4 µm ; Qe = 1.4
Nota: Esta determinación se ha hecho en base a las Claves de Funga Nórdica, sin embargo las medidas esporales citadas en las mismas Claves se encuentran por encima de mi propuesta (5-6 x 3.5-4 μm), no obstante en "Les Champignons de Suisse" se citan unas medidas esporales para el Agaricus semotus de 4,4-5,6 x 3,1-3,9 um. estas medidas encajarían a la perfección con las obtenidas en el presente estudio, según la descripción original estas esporas aún deberían ser algo más pequeñas (4-5 x 2,5-3,5 μm.) aunque también concordarían perfectamente con las del estudio.
Este Agaricus se caracterizaría por los tonos vinosos del sombrero, su pie bulboso, sus muy pequeñas medidas esporales y por las hifas vesiculosas de la arista laminar, dejo un pantallazo de "Les Champignons de Suisse" donde he remarcado este detalle:
Seguimos con más "cromos nuevos" de este día:
Una Lepiota, atendiendo a las Claves de Funga Nordica, me conducen a la Lepiota oreadiformis
Sus esporas con unas medidas de:
(9.3) 9.5 - 13.1 (14.3) × (4.5) 4.8 - 5.7 (6.1) µm
Q = (1.8) 1.9 - 2.3 (2.8) ; N = 35
Me = 11.2 × 5.3 µm ; Qe = 2.1
Y un Chroogomphus que no había tenido ocasión de estudiar aún, con sombrero seco y base del pie amarilleante con la manipulación, probablemente el Chroogomphus helveticus. Las imágenes son de estudio ya que con las prisas no les saqué fotos en su hábitat
Sus esporas con unas medidas en agua de:
(15.9) 16.2 - 18.7 (19.4) × (4.8) 5.1 - 5.6 (5.9) µm
Q = (2.8) 3 - 3.5 (3.6) ; N = 36
Me = 17.5 × 5.4 µm ; Qe = 3.2
Seguimos con más cosas que ya había estudiado anteriormente:
Una Amanita muy abundante durante toda la mañana, con el borde estriado, sin anillo y esporas globosas, probablemente Amanita vaginata
En este nuevo estudio sus esporas con unas medidas de:
(9.2) 9.9 - 12.2 (13) × (7.7) 8.5 - 10.7 (11.8) µm
Q = 1 - 1.26 (1.3) ; N = 30
Me = 11.1 × 9.7 µm ; Qe = 1.1
Un Cystoderma que solo había tenido ocasión de estudiarlo una vez, con olor desagradable, el Cystoderma carcharias
En este estudio sus esporas con unas medidas de:
(3.9) 4.5 - 5.4 (5.6) × (3.4) 3.43 - 3.9 (4.1) µm
Q = (1.1) 1.2 - 1.4 ; N = 40
Me = 4.9 × 3.7 µm ; Qe = 1.3
Una Inocybe. con caulosictidios por toda la superficie del pie, pleurocistidios presentes y esporas muy nodulosas que hace difícil su medición, el Inocybe mixtilis
Sus esporas con unas medidas de:
(6.9) 7.4 - 8.9 (9.2) × (4) 4.3 - 5.5 (5.7) µm
Q = (1.3) 1.5 - 2 (2.2) ; N = 30
Me = 8.2 × 4.8 µm ; Qe = 1.7
Otra Lepiota, en esta ocasión bajo coníferas, muy parecida a la Lepiota clypeolaria pero con esporas un poco más largas y un cociente Q por encima, la Lepiota magnispora:
Sus esporas en este estudio con unas medidas de:
(13.5) 15.1 - 17.8 (19.2) × (3.9) 4.3 - 5.2 (5.5) µm.
Q = (2.9) 3.2 - 3.8 (4) ; N = 30
Me = 16.2 × 4.7 µm ; Qe = 3.4
Un Leucopaxillus muy abundante, con esporas verrucosas y amiloides, el Leucopaxillus paradoxus:
Sus esporas con unas medidas de:
(6) 6.3 - 7.3 (7.9) × (4.2) 4.4 - 5.1 (5.4) µm
Q = (1.3) 1.35 - 1.5 (1.6) ; N = 30
Me = 6.8 × 4.7 µm ; Qe = 1.4
Una Pholiota, con pleurocistidios presentes tipo crisocistidio, la Pholiota jahnii
Sus esporas con unas medidas de:
(5.1) 5.4 - 6.2 (6.7) × (3.6) 3.7 - 4.2 (4.4) µm
Q = (1.3) 1.33 - 1.56 (1.6) ; N = 40
Me = 5.8 × 4 µm ; Qe = 1.4
Y ya seguimos con unas cuantas más del mismo día que ya ni me molesté en pasar por el micro:
Una Clitocybe, la Clitocybe alexandri, con esta me acabo de enterar que a partir de ahora la debemos denominar como Clitopaxillus alexandri, tocará pues rectificar archivos:
Muy abundante también los "rovellons", Lactarius deliciosus
Y ya a partir de 1800 metros y de menor tamaño que el anterior tenemos el Lactarius quieticolor
De enorme tamaño, una Macroprocera, medió tanta pena que ni la toqué, se quedó allí:
Muy vistosa y fotogénica como siempre, la Tricholomopsis rutilans
Y ya para terminar y a modo de alfombra por donde pisaba una Xeromphalina, toda la vida comprobando si era o no amarga y observando si llevaba rizoides o no en el pie, para poder separarla de la Xeromphalina fellea y ahora resulta que ambas son sinónimos, la Xeromphalina cauticinalis, particularmente a mí siempre me han parecido amargas, más o menos pero "amargas", jamás he encontrado una de dulce.
Saludos a tod@s.
Un solo ejemplar de Agaricus de la sección Minores de unos 3 cm., con sombrero con tonos vinosos:
Agaricus semotus Fr. (1863)
Suprapellis en agua del grifo:
Hifas vesiculosas a modo de queilocistidios en la arista laminar, pleurocistidios no observados:
Himenio con basidios tetraspóricos:
Las esporas en agua de grifo:
Y las esporas en Reactivo de Melzer (dextrinoides):
Las esporas en agua con unas medidas de:
(3.9) 4.4 - 5.1 (5.5) × (3) 3.2 - 3.6 (3.8) µm
Q = (1.3) 1.31 - 1.5 (1.6) ; N = 40
Me = 4.7 × 3.4 µm ; Qe = 1.4
Nota: Esta determinación se ha hecho en base a las Claves de Funga Nórdica, sin embargo las medidas esporales citadas en las mismas Claves se encuentran por encima de mi propuesta (5-6 x 3.5-4 μm), no obstante en "Les Champignons de Suisse" se citan unas medidas esporales para el Agaricus semotus de 4,4-5,6 x 3,1-3,9 um. estas medidas encajarían a la perfección con las obtenidas en el presente estudio, según la descripción original estas esporas aún deberían ser algo más pequeñas (4-5 x 2,5-3,5 μm.) aunque también concordarían perfectamente con las del estudio.
Este Agaricus se caracterizaría por los tonos vinosos del sombrero, su pie bulboso, sus muy pequeñas medidas esporales y por las hifas vesiculosas de la arista laminar, dejo un pantallazo de "Les Champignons de Suisse" donde he remarcado este detalle:
Seguimos con más "cromos nuevos" de este día:
Una Lepiota, atendiendo a las Claves de Funga Nordica, me conducen a la Lepiota oreadiformis
Sus esporas con unas medidas de:
(9.3) 9.5 - 13.1 (14.3) × (4.5) 4.8 - 5.7 (6.1) µm
Q = (1.8) 1.9 - 2.3 (2.8) ; N = 35
Me = 11.2 × 5.3 µm ; Qe = 2.1
Y un Chroogomphus que no había tenido ocasión de estudiar aún, con sombrero seco y base del pie amarilleante con la manipulación, probablemente el Chroogomphus helveticus. Las imágenes son de estudio ya que con las prisas no les saqué fotos en su hábitat
Sus esporas con unas medidas en agua de:
(15.9) 16.2 - 18.7 (19.4) × (4.8) 5.1 - 5.6 (5.9) µm
Q = (2.8) 3 - 3.5 (3.6) ; N = 36
Me = 17.5 × 5.4 µm ; Qe = 3.2
Seguimos con más cosas que ya había estudiado anteriormente:
Una Amanita muy abundante durante toda la mañana, con el borde estriado, sin anillo y esporas globosas, probablemente Amanita vaginata
En este nuevo estudio sus esporas con unas medidas de:
(9.2) 9.9 - 12.2 (13) × (7.7) 8.5 - 10.7 (11.8) µm
Q = 1 - 1.26 (1.3) ; N = 30
Me = 11.1 × 9.7 µm ; Qe = 1.1
Un Cystoderma que solo había tenido ocasión de estudiarlo una vez, con olor desagradable, el Cystoderma carcharias
En este estudio sus esporas con unas medidas de:
(3.9) 4.5 - 5.4 (5.6) × (3.4) 3.43 - 3.9 (4.1) µm
Q = (1.1) 1.2 - 1.4 ; N = 40
Me = 4.9 × 3.7 µm ; Qe = 1.3
Una Inocybe. con caulosictidios por toda la superficie del pie, pleurocistidios presentes y esporas muy nodulosas que hace difícil su medición, el Inocybe mixtilis
Sus esporas con unas medidas de:
(6.9) 7.4 - 8.9 (9.2) × (4) 4.3 - 5.5 (5.7) µm
Q = (1.3) 1.5 - 2 (2.2) ; N = 30
Me = 8.2 × 4.8 µm ; Qe = 1.7
Otra Lepiota, en esta ocasión bajo coníferas, muy parecida a la Lepiota clypeolaria pero con esporas un poco más largas y un cociente Q por encima, la Lepiota magnispora:
Sus esporas en este estudio con unas medidas de:
(13.5) 15.1 - 17.8 (19.2) × (3.9) 4.3 - 5.2 (5.5) µm.
Q = (2.9) 3.2 - 3.8 (4) ; N = 30
Me = 16.2 × 4.7 µm ; Qe = 3.4
Un Leucopaxillus muy abundante, con esporas verrucosas y amiloides, el Leucopaxillus paradoxus:
Sus esporas con unas medidas de:
(6) 6.3 - 7.3 (7.9) × (4.2) 4.4 - 5.1 (5.4) µm
Q = (1.3) 1.35 - 1.5 (1.6) ; N = 30
Me = 6.8 × 4.7 µm ; Qe = 1.4
Una Pholiota, con pleurocistidios presentes tipo crisocistidio, la Pholiota jahnii
Sus esporas con unas medidas de:
(5.1) 5.4 - 6.2 (6.7) × (3.6) 3.7 - 4.2 (4.4) µm
Q = (1.3) 1.33 - 1.56 (1.6) ; N = 40
Me = 5.8 × 4 µm ; Qe = 1.4
Y ya seguimos con unas cuantas más del mismo día que ya ni me molesté en pasar por el micro:
Una Clitocybe, la Clitocybe alexandri, con esta me acabo de enterar que a partir de ahora la debemos denominar como Clitopaxillus alexandri, tocará pues rectificar archivos:
Muy abundante también los "rovellons", Lactarius deliciosus
Y ya a partir de 1800 metros y de menor tamaño que el anterior tenemos el Lactarius quieticolor
De enorme tamaño, una Macroprocera, medió tanta pena que ni la toqué, se quedó allí:
Muy vistosa y fotogénica como siempre, la Tricholomopsis rutilans
Y ya para terminar y a modo de alfombra por donde pisaba una Xeromphalina, toda la vida comprobando si era o no amarga y observando si llevaba rizoides o no en el pie, para poder separarla de la Xeromphalina fellea y ahora resulta que ambas son sinónimos, la Xeromphalina cauticinalis, particularmente a mí siempre me han parecido amargas, más o menos pero "amargas", jamás he encontrado una de dulce.
Saludos a tod@s.
Adjuntos:
El siguiente usuario dijo gracias: Juan Andrés Román, Pepe Ferrer
Por favor, Identificarse para unirse a la conversación.
- Juan Andrés Román
-

- Fuera de línea
- Spammer
-

Menos
Más
- Mensajes: 2558
- Gracias recibidas: 2756
4 años 6 meses antes #106326
por Juan Andrés Román
Respuesta de Juan Andrés Román sobre el tema Agaricus semotus y más cosas del pasado domingo.
Buena tirada figura....Un abrazo................
El siguiente usuario dijo gracias: Josep Torres
Por favor, Identificarse para unirse a la conversación.
- Foro
- Foros sobre Micología de fungipedia
- Microscopía
- Agaricus semotus y más cosas del pasado domingo.
Tiempo de carga de la página: 0.198 segundos

Foro de micología